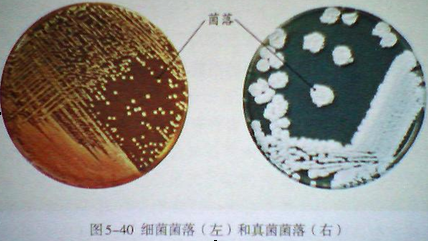
fd4880c94b82c393775410125670de1b.png

|
|
第一节 细菌和真菌的分布
年级:八年级 课型:新授课 时间:20年月日 班级:
学习目标:
1、说出细菌和真菌分布的特点。
2、尝试采用细菌和真菌培养的一般方法,进行 “检测不同环境种的细菌和真菌”的探究活动。
学习重点:
1.检测不同环境种的细菌和真。
2. 说出细菌和真菌分布的特点,菌和真菌的分布
学习难点:
检测不同环境种的细菌和真菌
预习案
预习案
一 、预习提纲
1.细菌和真菌的分布范围是怎样的
2.怎样检测环境中的细菌和真菌
二、预习检测:(自学检测)
1、菌落就是由一个或繁殖后形成的肉眼可见的集合体。
2、看图5-40填空,细菌的菌落比较,表面或。
3.真菌的菌落一般比细菌菌落。
4.真菌中的霉菌形成的菌落常呈状、状或状,有时还呈现出、、、、等不同的颜色。
5.从菌落的、和可以大致区别细菌和真菌。
6.细菌、真菌培养的一般方法:首先是配制含有营养物质的,然后是对它和用具进行,在它冷却到室温后进行,最后是对接入细菌或真菌进行恒温。
7.细菌和真菌生存所需的条件有、和,有的还需要或一定不需要。
【展示交流】分小组交流以上内容
行课案
【合作探究】
1.养鸡场的饲养员为什么要穿白大褂,农民伯伯给散养的鸡喂食为什么不穿白大褂?
2.为什么培养用细菌时选用的培养皿和培养基,在接种前必须高温处理?为什么要用无菌棉棒? 在培养细菌时,没有想好如何具体工作,为什么不要打开灭菌后的培养皿?
3.为什么要准备两套装有培养基的培养皿?
4. 两套装有培养基的培养皿,为什么要放在同一环境中培养?
5. 四川的泡菜很有名,味道酸,能增进人的食欲。制作泡菜的原理就是利用乳酸菌使蔬菜中的有机物生成乳酸。泡菜坛的结构,既要加盖,还要用一圈水来封口,请推测其中的科学道理。
检测案
一、课堂检测
1、一个细菌或真菌繁殖的后代形成的肉眼能够看见的集合体被称为 ( )
A 真菌 B 细菌 C 菌落 D 菌痕
2、在一个培养皿中有大大小小许多个细菌及真菌的菌落,细菌菌落的特征是 ( )
A 面积比较大,呈绒毛状 B 面积比较小,表面光滑粘稠
C 面积比较大,呈蜘蛛网状 D 面积比较小,表面絮状
3、在培养基中加入牛肉汁、琼脂是为了 ( )
A 使培养基闻起来更香,容易吸引细菌
B 使培养基的表面看起来很粘稠
C 为细菌等生物的生活过程提供水分和无机盐
D 为细菌等生物的生活提供有机物
4、“打开培养皿,暴露在空气中5-10分钟,再盖上盖,封好”过程中相当于细菌培养的那一个步骤 ( )
A 恒温培养 B 接种 C 消毒 D 制作培养基
5、细菌和真菌能在恒温箱中的培养基上迅速繁殖,形成肉眼可见的菌落,其原因是 ( )
A 恒温箱提供了适宜的温度 B 培养基中含有有机物
C培养基中含有水分 D 是A、B、C、三项满足了细菌、真菌生存的需要
6、某人制作泡菜,操作不当致使泡菜腐烂,其解释中正确的是 ( )
A 罐口密封缺氧,抑制了乳酸菌的生长繁殖
B 罐口密封不严,氧气促进了乳酸菌的快速繁殖
C 罐口密封不严,氧气抑制了其他腐生菌的生长繁殖
D 罐口密封不严,促进了需氧细菌的生长繁殖
7、在检测某处细菌、真菌时,要准备两套培养皿,原因是 ( )
A 一套培养皿万一不能采集到细菌、真菌,可用另一套备用的再采集
B 两套培养皿做实验可获得更多的细菌、真菌
C 一套培养皿做实验,另一套作对照
D 准备两套是为了防止意外,如不小心打碎等
8、我国民间常有盐渍法来保存食品,其中生物学原理是 ( )
A 食盐可以使细菌毒素失效 B 食盐中缺乏细菌需要的营养
C 食盐中有杀菌物质 D 食盐使细菌细胞脱水死亡
二、课后检测:独立完成练习册本节作业,包括【探究与思考】。
|
|
![]() 川公网安备51152402000101号 )|网站地图
川公网安备51152402000101号 )|网站地图